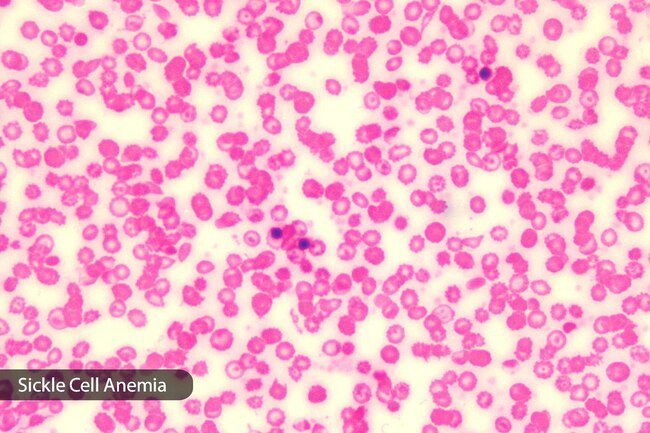
It's common to feel tired, weak, and cold when you have anemia.

Cold, Flu, and Cough: Why Do I Have the Chills Other Than Fever?
Heavy Exercise

Physical activity that's really intense or lasts for a long time can raise your body temperature. Heat exhaustion, or exertional heat illness, might give you chills. You may feel confused or your muscles may be hard to control. You might get diarrhea or vomit, or faint.
Underactive Thyroid

The thyroid is a small butterfly-shaped gland in your neck. It puts out hormones to help control how your body uses energy. You might have a condition called hypothyroidism if it's not working the right way. Symptoms include tiredness, constipation, and a low heart rate. You might also have trouble dealing with cold. You may get chills as a result.
Hypoglycemia

That's when your blood sugar dips below healthy levels. Sweating, chills, and clamminess can all be signs. You may feel shaky, weak, irritable, hungry, and nauseous until you get your blood sugar back up.
Malaria

This is an infection caused by a parasite. It happens when an infected mosquito bites you. Malaria does cause a fever, but chills often come first. Some people have several attacks. That's when you get chills, a fever, start sweating, then return to normal. It happens over and over.
Kidney Stones

They're minerals and salts that clump together in hard deposits inside your kidneys. Your body passes them through your ureters to get rid of them. Those are the tubes that connect your kidney and bladder. Sometimes the stones get stuck and cause infection. That may bring on chills, nausea, and fever.
Hypothermia

When you're in very cold temperatures for a long time, your body loses heat faster than it can make it. This is what leads to hypothermia. Shivering chills is one of the symptoms. You might have memory loss and slurred speech. You may also be confused and feel sleepy.
Emotional Reactions

When you have intense feelings about something, you might feel "shivers down your spine" or goosebumps. This is called "frisson" or a "skin orgasm." It involves a release of dopamine from your brain. You might have this type of chill when you're scared or hear a song you really like.
Panic Attack

A panic attack doesn't just affect your mind. You can have physical symptoms, too. They might include trouble breathing, sweating, and dizziness. You may also get chest pain and chills. Sometimes people think a panic attack is a heart attack because the symptoms can be the same.
Post-Surgery Side Effect

You might shiver when you wake up if you've been under anesthesia. That's because your body temperature may have dropped during surgery. Once you're awake, your body starts to heat back up. The chills should go away after 20-30 minutes.
Multiple Sclerosis

That's a disease that attacks your central nervous system. Symptoms can include numbness and tingling. Or you may have a burning "pins and needles" feeling. You might also become much more sensitive to temperature and feel cold easily.
Anemia
It happens when your body doesn't have enough red blood cells, so it can't carry the right amount of oxygen to your tissues. It's common to feel tired, weak, and cold when you have anemia. These symptoms can get worse if your anemia does.
Malnutrition

Certain vitamins and minerals help keep your body at the right temperature. That's called thermoregulation. Zinc, copper, and iron all play a part. If you're running low, you may feel cold and easily catch a chill.
Cold, Flu, and Cough: Why Do I Have the Chills Other Than Fever?
IMAGES PROVIDED BY:
- Getty
- Getty
- Getty
- Getty
- Getty
- Getty
- Getty
- Getty
- Getty
- Getty
- Getty
- Getty
REFERENCES:
- USC Keck School of Medicine: "5 Reasons Why You Might Have the Chills."
- National Institute of Diabetes and Digestive and Kidney Diseases: "Hypothyroidism (Underactive Thyroid)."
- American Diabetes Association: "Hypoglycemia (Low Blood Sugar)."
- Mayo Clinic: "Malaria," "Kidney stones," "Anemia."
- CDC: "Hypothermia."
- Frontiers in Psychology: "Thrills, chills, frissons, and skin orgasms: toward an integrative model of transcendent psychophysiological experiences in music."
- Royal College of Anesthetists: "Shivering."
- Pharmacy and Therapeutics: "Multiple Sclerosis Review."
- Medicine & Science in Sports & Exercise: "Exertional Heat Illness during Training and Competition."
- Marriott BM, Carlson SJ. Nutritional Needs In Cold And In High-Altitude Environments: Applications for Military Personnel in Field Operations, National Academies Press, 1996.
- University of Connecticut: "Heat Exhaustion."
© 1996-2022 WebMD, LLC. All rights reserved.
Source slideshow on WebMD
